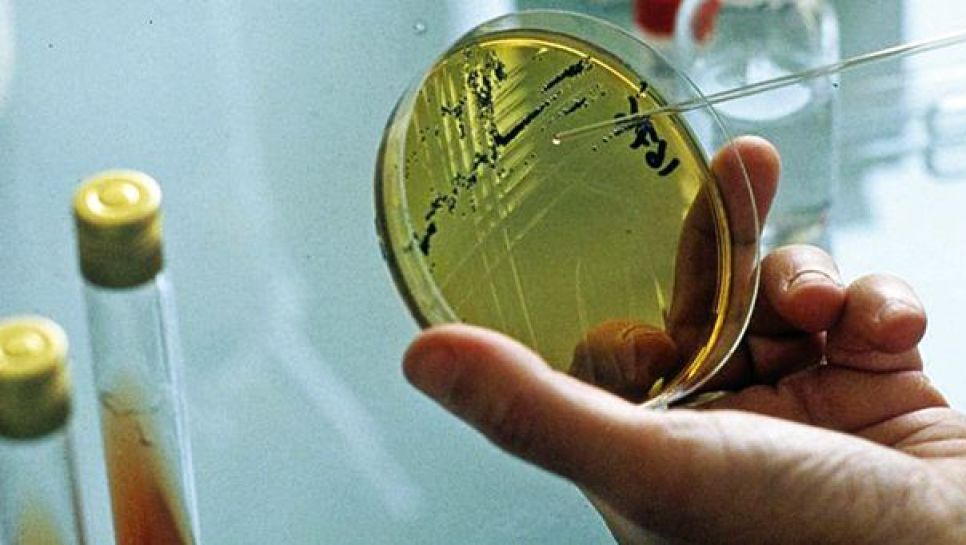
© D. R.

■ Après une brève opération expérimentale lancée auparavant pour des analyses physico-chimiques, le laboratoire de contrôle de la qualité implanté dans la nouvelle ville d’Akid-Othman n’a toujours pas ouvert ses portes et ce, après plus de cinq années.
Ce qui a poussé le président de la commission économie et finances de l’APW d’Aïn Témouchent à s’interroger sur ce retard qui pénalise la direction du commerce, obligée de transférer les échantillons des produits incriminés vers les laboratoires d’Oran, de Tlemcen et même de la capitale, occasionnant des dépenses colossales.
Selon Guidji Abderrahmane, directeur du commerce de la wilaya d’Aïn Témouchent, cette infrastructure, dont l’équipement et la gestion relèvent de la direction générale du Centre algérien de contrôle de la qualité et de l’emballage (CACQE), nécessite une enveloppe financière estimée à près de 3 millions de dinars pour l’achèvement des travaux de la partie réservée aux analyses microbiologiques.
“Le wali nous a donné son accord de principe qui nous a permis de lancer la procédure pour l’inscription de l’opération”, a-t-il précisé. La mise en service de ce laboratoire participera effectivement à faire face aux intoxications alimentaires.
Il participe aussi dans la rationalisation des dépenses destinées aux déplacements vers les laboratoires des wilayas avoisinantes, dont ceux d’Oran, de Tlemcen et même d’Alger.






